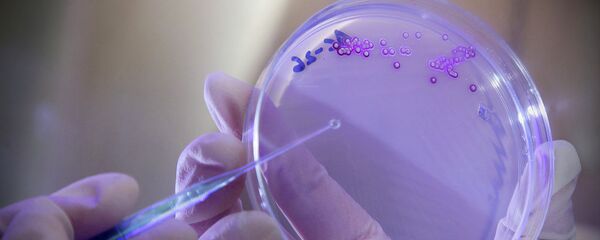
Бактерије - Sputnik Србија

Муве носе 200 облика штетних бактерија на ногама, наводе стручњаци.
Онe пренoсe те бактерије на храну, чак и ако је само на тренутак додирну.
Такође, муве испуштају и дигестивне ензиме на храну, а онда их поново једу.
Пролеће и лето доносе топло време и сунце, али и стварају услове за најезду иритирајућих мува које покушавају да слете на храну.
Муве привлаче остаци хране и измет, као и веома слатке супстанце попут презрелог воћа и проливеног газираног пића.
Утврђено је да на хиљадама ситних длачица на ногама муве у просеку носе више од 200 облика штетних бактерија.
Могу да пренесу озбиљне, заразне болести попут колере, дизентерије и тифуса.
Извор: Дејли мејл